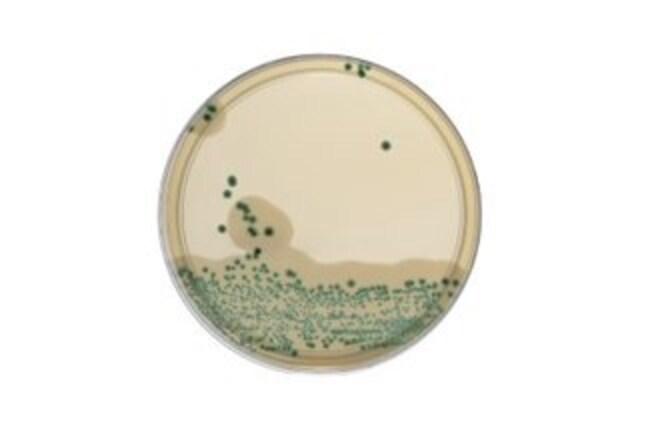
<p>Oxoid™ <i>Brilliance</i>™ 李斯特菌琼脂 (ISO) 平板</p>

Search
Search
Oxoid™ Brilliance™ 李斯特菌琼脂 (ISO) 平板
使用这款显色培养基分离、计数和初步鉴定李斯特菌属和单核细胞增生李斯特菌。
| 货号 | 原产国 |
|---|---|
| PO1298A | 英国 |
| PO5332A | 德国 |
在肉汤富集后,使用 Thermo Scientific™ Oxoid™ Brilliance™ 李斯特菌琼脂 (ISO) 制备的平板,从食品和环境样本中分离、计数和初步鉴定李斯特菌属和单核细胞增生李斯特菌。该培养基鉴定李斯特菌属的依据是,李斯特菌会利用 X-葡萄糖苷形成蓝绿色菌落。单核细胞增生李斯特菌能产生大量卵磷脂酶,进而在菌落周围形成不透明的白色晕圈,由此得以进一步区分。
使用 Thermo Scientific™ Brilliance™ 李斯特菌琼脂 (ISO) 平板来分离、计数和初步鉴定李斯特菌属和单核细胞增生李斯特菌。
Oxoid Brilliance 李斯特菌琼脂使用 X-葡萄糖苷发色剂来初步鉴定李斯特菌属。该发色剂可被所有李斯特菌属共有的 ß-葡萄糖苷酶裂解。其他含有该酶的微生物(如肠球菌)受到培养基中的选择性试剂抑制:氯化锂、多粘菌素 B 和萘啶酸,而两性霉素则抑制样本中存在的任何酵母菌和霉菌的生长。单核细胞增生李斯特菌和致病性伊氏李斯特菌能够产生磷脂酶(卵磷脂酶),随后可借此进一步区分它们。 该酶可水解培养基中的卵磷脂,在菌落周围产生不透明的白色晕圈。
Oxoid Brilliance 李斯特菌琼脂 (ISO) 的配方和性能符合 ISO 11290-1:2017 和 ISO 11290-2:2017 李斯特菌属和单核细胞增生李斯特菌检测和计数参考方法。
相较于 ISO 11290-1:2017 和 ISO 11290-2:2017 方法,我们已根据 ISO 16140-2,按照 NF 验证规则将 Oxoid Brilliance 李斯特菌琼脂 (ISO) 作为 Thermo Scientific™ 李斯特菌 Precis™ 方法的一部分针对许多样本进行了验证。
Thermo Scientific™ Oxoid™ Brilliance™ 李斯特菌琼脂 (ISO)